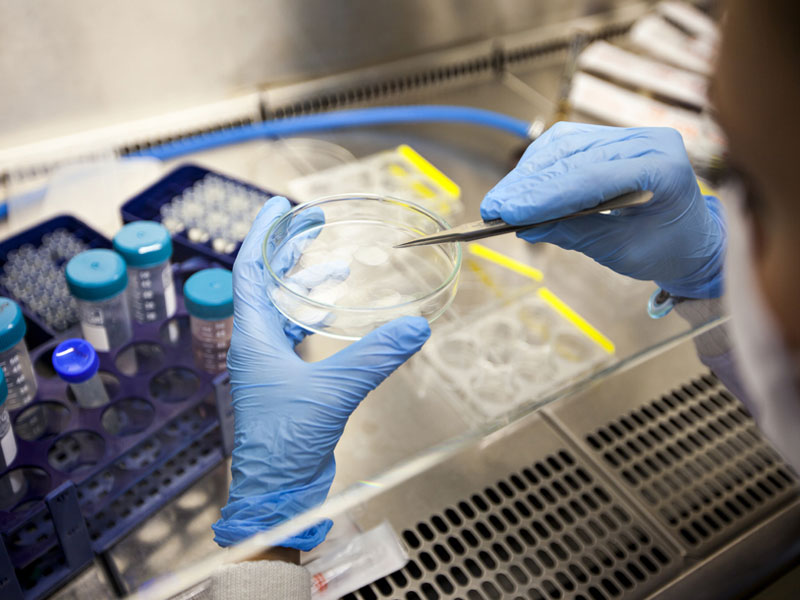

ලොව පුරා මිලියන 40කට ආසන්න පිරිසකට වැළඳී ඇති HIV වෛරසයට සම්පූර්ණ ප්රතිකාරයක් සෙවීමේ අභියෝගය ජය ගැනීම සඳහා නව පියවරක් සොයාගෙන තිබේ.
මෙල්බර්න් විශ්ව විද්යාලය සහ රාජකීය මෙල්බර්න් රෝහල අතර ඒකාබද්ධ ව්යාපාරයක් වන පීටර් ඩොහර්ටි ආසාදන හා ප්රතිශක්තිකරණ ආයතනයේ (Doherty Institute) වෛද්ය පෝලා සෙවාල් සහ ඇගේ කණ්ඩායමයි එය සිදුකර ඇත්තේ.
Resting T‐cells ලෙස හැඳින්වෙන නිශ්චිත ප්රතිශක්තිකරණ සෛල තුළ නිශ්චලව සිටිමින් HIV ප්රතිකාර නතරවුවහොත් නැවත මතුවන වෛරසය නිරීක්ෂණය කිරීම සඳහා මාර්ගයක් ඔවුන් සොයාගෙන තිබේ.
ආසාදිත සෛලවලට වෛරසය ‘අත්හැර’ එය පෙන්නුම් කරන ලෙස පැවසීමට mRNA තාක්ෂණ වැඩසටහනින් උපදෙස් දුන් නමුත් එම සෛල තුළට mRNA ලබා ගැනීම අභියෝගයක්ව පැවතුණි.
HIV සඳහා ප්රතිකාරයක් සොයා ගැනීමට එය ප්රධාන බාධකය වී තිබේ.
එහෙත් මෙම සොයා ගැනීමකදී, වෛද්ය කණ්ඩායම mRNA තාක්ෂණය භාවිතයෙන් වෛරසය නිරාවරණය කිරීමට ක්රමයක් සොයාගනු ලැබුවේය.
ඔවුන් mRNA සඳහා බෙදා හැරීමේ වාහකයක් ලෙස නව ලිපිඩ නැනෝ අංශුවක් සංවර්ධනය කර තිබේ.
ඉන් HIV ආසාදිත සෛල තුළට mRNA සාර්ථකව රැගෙන යා හැකි බවයි ඔවුන් හෙළි කරගෙන ඇත්තේ.
එහිදී වෛරසය සැඟවීමකින් තොරව පිටතට පැමිණීමට පීඩනයක් එල්ල කර ඇති අතර වෛරසය ශරීරයෙන් ඉවත් කිරීම ආරම්භ කිරීමේ පළමු පියවර එය බවයි පර්යේෂකයින් පවසන්නේ.
ඔවුන් පෙන්වා දෙන්නේ මෙම නව නැනෝ අංශු නිර්මාණය අනාගත HIV ප්රතිකාර උපාය මාර්ගවල ප්රධාන සාධකයක් විය හැකි බවටයි.